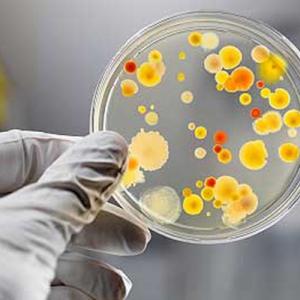
picture 1

Executive Board
The current OWSD Executive Board was elected in June-July 2021 in an online election. The Executive Board consists of a President, four Vice Presidents, four Regional Members, and the immediate past President. There is one Vice President and one Regional Member from each of the four OWSD regions